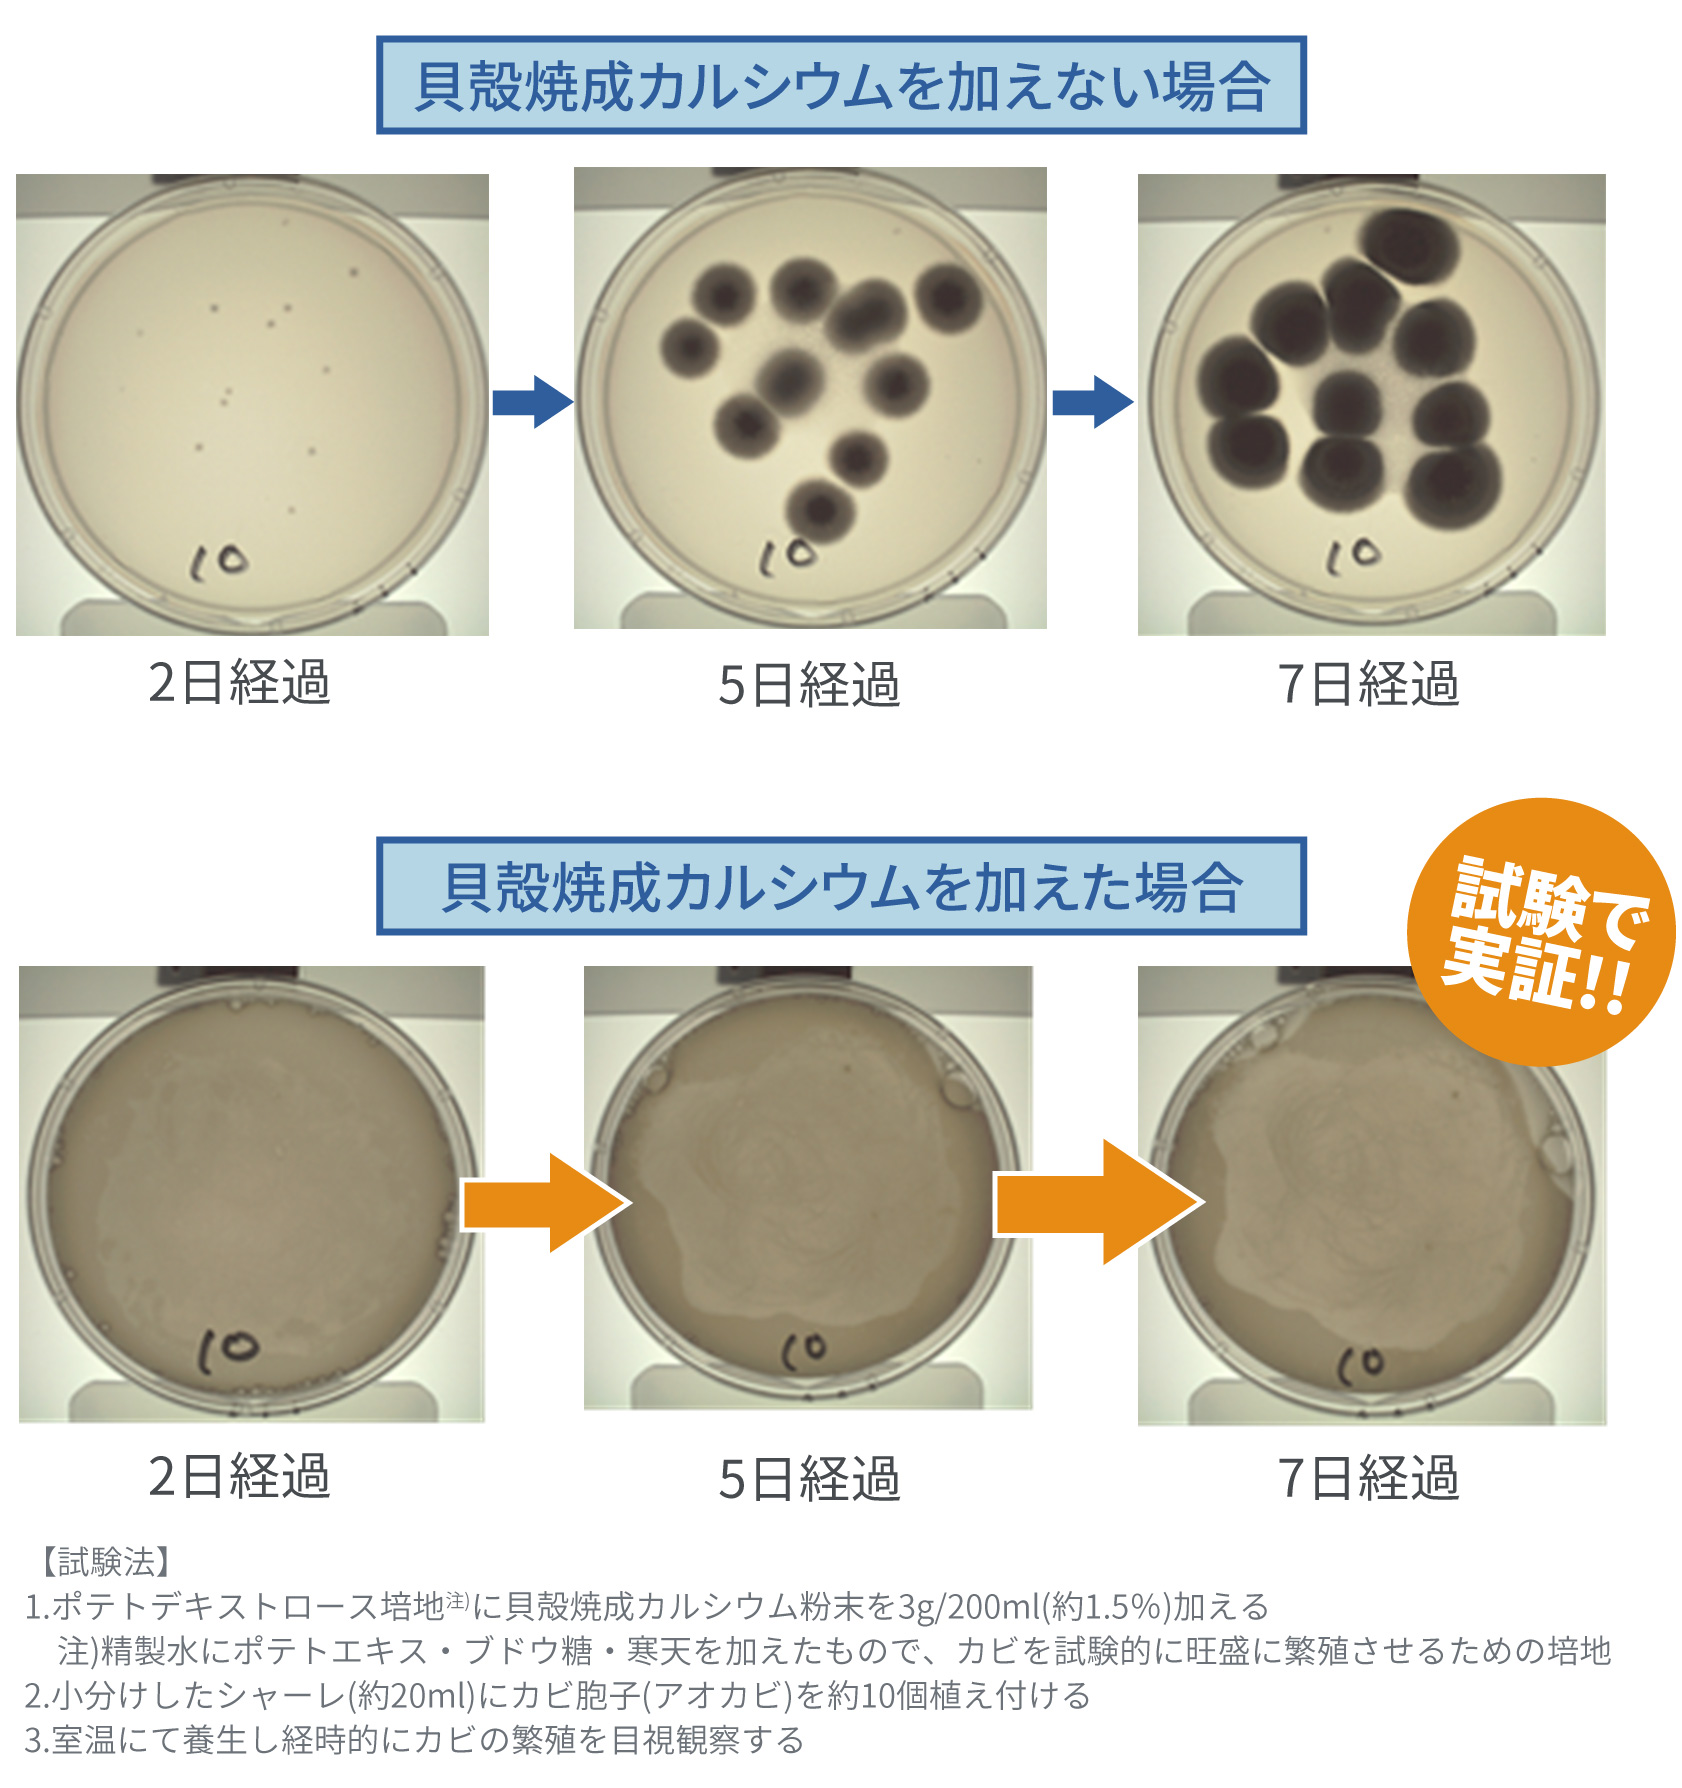
抗カビ試験結果の一例

毎日使うものだから、家族や大切なひとのために使うものだから。納得して使えるもの、満足できるものを選びたいと思うのは当然のこと。シェリスタは自然の力で活躍する100%ナチュラルな製品です。

シェリスタは北海道オホーツク海産のホタテ貝殻のみを原料とした天然素材100%でつくられています。合成界面活性剤・保存料・着色料・香料は一切使用していません。

シェリスタの成分は「食品添加物」として北海道薬剤師会公衆衛生検査センターから認定を受けています。食品添加物に使えるくらいなので、もし誤って赤ちゃんやペットが少し舐めてしまっても重篤な問題になることはありません。また皮膚刺激試験でも蒸留水よりも刺激が少ないという結果も出ています。

シェリスタは塩素系除菌剤のような刺激臭もなく頭痛や臭いも気にする必要はありません。また誤って他の除菌剤と併用して有毒ガスが発生してまう、いわゆる「まぜるな危険」が起こることはありません。

北海道のオホーツク海沿岸ではMSC認証漁業のホタテ養殖がとても盛んです。しかしホタテ貝の養殖漁増加に伴い、大量のホタテ貝殻が廃棄されています。オホーツク海のホタテ漁獲高30万トンのうち、半数の15万トンにものぼるホタテ貝殻が産業廃棄物として廃棄されている現状があります。このように廃棄されているホタテ貝殻を有効利用するため、ホタテ貝殻を丁寧に洗浄消毒してリユースすることで、人にも環境にも優しい商品としてシェリスタを作りました。天然素材なので排水口に流しても河川や土壌を汚染することはありません。これからの未来に要求される環境循環型(サステイナブル)の商品です。



社会貢献として養護施設の方達の就労支援を生産工場で実施しております。シェリスタの容器の中に素材を詰める作業を養護施設の人達が、一生懸命に詰めてくれています。シェリスタパウダーは100gを測って一つずつ手作業で入れます。また、シェリスタスプレーも大きな液体のタンクから250mlを測り、これを1本ずつ手作業にて入れています。シェリスタは地域に密着した社会貢献活動にも取り組んでおります。


シェリスタの成分「貝殻焼成カルシウム」とは、ホタテ貝の貝殻を1000度以上の高温で熱した後に加水した強アルカリ性(pH12.5~13.2)の水酸化カルシウムです。この強アルカリ性はタンパク質を分解する性質があるため、病原菌やウィルスの細胞壁に含まれるタンパク質を破壊し、菌類を死滅させることができます。
この除菌・抗カビ効果を利用して、野菜や果物やお米、キッチンやトイレ、赤ちゃん用品やペット用品、お風呂や洗濯機、車や家具といった日常生活の幅広いシーンで、シェリスタの成分「貝殻焼成カルシウム」は除菌剤として活躍してくれます。
乳幼児や高齢者は食中毒から重篤化する可能性もありますので、日常的に適切な除菌を行うのが望ましいとされています。シェリスタの成分「貝殻焼成カルシウム」は高いアルカリ性の力によってウイルスや細菌を除菌します。さまざまな細菌も数分程度で除菌されます。さらに近年猛威をふるっている非エンベロープタイプウイルスに対しても同様に数分で除菌されます。(※すべての菌やウイルスを除去するわけではありません)

梅雨や夏に問題になるカビの繁殖も抑える効果があります。カビは放置したままにしておくと、カビを吸い込むことで気管支炎喘息や鼻炎、頭痛や発熱といった症状が出てくることもあります。カビ対策で大切なことは、カビが発生する前から適切な対処をすることです。シェリスタの成分「貝殻焼成カルシウム」にはアオカビ・コウジカビ・クロコウジカビといったカビ菌の繁殖を抑える効果もあります。湿気の気になるところに毎日使用することで、抗カビ効果が期待できます。
臭いを香りで包むマスキング方式の消臭剤や消臭スプレーと違い、香料を含まないシェリスタは臭いの原因を元から取り除きます。化学薬品は入っていない100%ナチュラル成分なので、使う場所を選ばずに臭いの気になるところへ使えるところも嬉しいポイントです。
キッチン周りやトイレ、灰皿やゴミ箱や冷蔵庫内、靴や下駄箱など使用用途は多岐に渡ります。その他にも赤ちゃんのおむつやお子さまが使うオモチャやぬいぐるみ、ペット用品や衣類や靴・靴下、自動車内のシートやカーペット、ソファなどの家具類といった日常生活で臭いが気になるところでご使用ください。

毎日使うものなのでボトルのデザインにもこだわりました。キッチンやリビングなどに置いても室内の雰囲気を損なわないよう、過度な装飾は省いてシンプルな佇まいにしています。




古代ペルシャ時代から使われている「青海波(せいがいは)」という文様と、主成分であるホタテ貝殻をモチーフにしてシェリスタのロゴマークはつくられています。青海波とは波を表した模様のことで、人びとの平穏な暮らしがいつまでも続くようにという願いが込められています。この青海波と同じように、シェリスタのマークにも「海の恵みを享受しながら、わたしたちが安心して暮らし続けられるように」という願いを込めています。
シェリスタは使用する用途に合わせて2種類ご用意しています。パウダータイプは、果物・野菜や哺乳びん、また洗濯機やお風呂などの除菌・洗浄用として。スプレータイプは、キッチンやトイレ、ベビー用品・ペット用品などの除菌・消臭用にお使いください。

シェリスタはJOCA推奨品マークを取得しています。
JOCA推奨品マークには、日本オーガニックコスメ協会独自の基準が定められています。
消費者の立場から、安心安全なオーガニックコスメを選びやすくすることを一番の目的としています。次にメーカーがより安全なオーガニックコスメを製造するさいの指針になることを目的として作られたものです。
さらには、このオーガニックコスメの推奨品マークの基準を伝えることにより、「衣食住」丸ごとオーガニックライフの普及に貢献することができると考えています。
シェリスタは天然素材100%で合成界面活性剤・保存料・着色料・香料など使用していない事が評価されました。
| 商号 | 株式会社newlogic |
| 代表取締役 | 船木大輔 |
| 設立 | 平成27年6月 |
| 所在地 | 〒105-0004 東京都港区新橋6-5-4 DIKマンション新橋908 |
| TEL | 03-6311-0870 (土日祝日を除く11:00-18:00まで) |
| 取引銀行 | 三井住友銀行 渋谷駅前支店 |